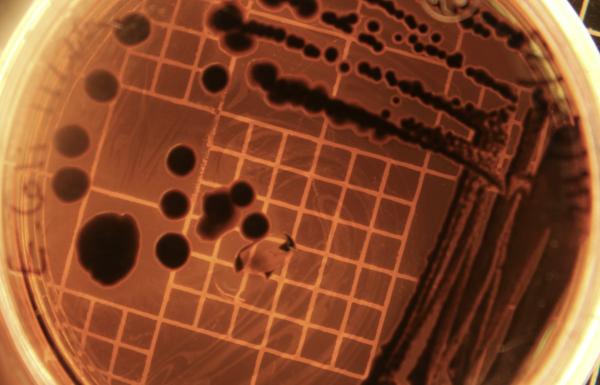

They used to call it “wool sorter’s disease” or “hide-porter’s disease” because the affliction struck workers who spun wool or carried animal skins. They would sometimes develop circular lesions on their skin with a coal black centre, hence the name of the disease “anthrax” from the Greek word for coal. In rare instances, drummers developed anthrax as they beat animal-skin drums.
The cause of the disease is infection by the bacterium Bacillus anthracis, which can cause severe illness and even death. Dormant forms of the bacterium known as spores can be found in the soil and contaminate the feed of grazing animals. Once ingested, the dormant forms revive and become live bacteria that then spew out toxins that cause the symptoms of the illness.
These symptoms depend on whether the spores or the live bacteria are inhaled, ingested, or invade the body through openings in the skin. Inhalation causes fever, shortness of breath, and chest pain, while ingestion results in diarrhea, nausea, vomiting, and abdominal pain. Inhalation is the most dangerous form of exposure. Luckily, the disease does not spread person to person, but people can become sick by eating infected animals.
The bacteria that cause the disease were first identified in 1876 when Robert Koch managed to grow them in culture and introduced them into animals that then got sick. From these animals, he re-isolated the microbes and showed they could infect other animals. This proved that the disease was indeed caused by the bacteria and led to “Koch’s postulates,” a set of criteria to establish a causal relationship between a specific micro-organism and a disease.
According to the postulates, the micro-organism must be found in all cases of the disease and absent in healthy individuals; it must be isolated from the diseased host and grown in pure culture, the pure culture must be introduced into a healthy, susceptible host, and it must reproduce the disease. Finally, the same micro-organism must be re-isolated from the experimentally infected host.
Koch also identified the bacteria that cause tuberculosis, for which he was awarded the 1905 Nobel Prize in physiology and medicine.
In 1881, following up on Koch’s work, Louis Pasteur infected 25 sheep with a weakened form of the bacterium and then challenged them with a virulent form. The sheep lived, while a control group of 25 sheep that had not been treated with the weakened version died. Pasteur had developed a vaccine against anthrax!
While much effort has focused on avoiding anthrax, human nature being what it is, history has also seen efforts to explore the use of the bacterial spores to inflict harm.
During the First World War, German saboteurs attempted to use anthrax to infect livestock and cavalry horses of Allied nations and neutral countries like Argentina that traded with the Allied forces. During the occupation of Manchuria (1932–1945), Japan tested the bacterial agent on prisoners of war and used aircraft to spray anthrax and other biological agents over at least 11 Chinese cities, contaminating homes and water supplies.
In 1942, the U.K., in coordination with the U.S. and Canada, launched Operation Vegetarian to test anthrax as a weapon. Eighty sheep were transported to the unoccupied Gruinard Island off the coast of Scotland, where they were exposed to anthrax by the detonation of bombs filled with anthrax spores. All the sheep were killed. However, by the time the bacteria were ready to be deployed, the Normandy Invasion had occurred, and Allied troops were advancing across northern Europe, causing Operation Vegetarian to be abandoned. The contamination of the island was so severe that it remained quarantined for 45 years until it was decontaminated in 1986 using formaldehyde.
In 1979, a military microbiology facility in Sverdlovsk in the Soviet Union accidentally released a plume of anthrax spores after workers failed to replace an air filter. The spores, carried by the wind, killed at least 68 people and numerous livestock.
The anthrax connection that most people would have heard of occurred in 2001 when, after the Sept. 11 attacks, letters containing anthrax spores were mailed to media offices and U.S. Senators. Release of the spores caused 11 cases of cutaneous anthrax and 11 cases of inhalation anthrax. Five of the inhalation victims died, while six other individuals with inhalation anthrax — and all the individuals with cutaneous anthrax recovered. Had it not been for antibiotic therapy, this number would likely have been higher.
Once anthrax spores had been identified in the letters, a massive cleanup was undertaken using a variety of chemicals. Hydrogen peroxide, ethylene oxide, chlorine dioxide, peracetic acid, sodium hydrochloride, methyl bromide and formaldehyde were all tested and found to be effective in killing the spores. An FBI investigation spanned seven years before federal prosecutors concluded that Army biodefense researcher Bruce Ivins, who committed suicide in 2008, was the sole perpetrator.
There have been a number of unusual infections. In the early 1900s, a number of men developed cutaneous lesions on their faces and necks after using goat-hair shaving brushes. Public health warnings led to the sterilization of the brushes that put an end to the problem. Another contamination problem cropped up in 2009 when a number of heroin addicts developed anthrax from injecting heroin that had been adulterated with animal products, probably bone meal. In 2016, on Russia’s Yamal Peninsula, a heat wave thawed a decades-old reindeer carcass, releasing spores and sparking an outbreak that killed a child and thousands of reindeer. Anthrax’s spore form is astonishingly durable — able to bide its time in soil and ice.
Bacteria are scary creatures. So are people. I’m afraid we will hear of some nefarious use of anthrax again.
# Reprinted with permission. Dr. Schwarcz’s original article can be found on the OSS website